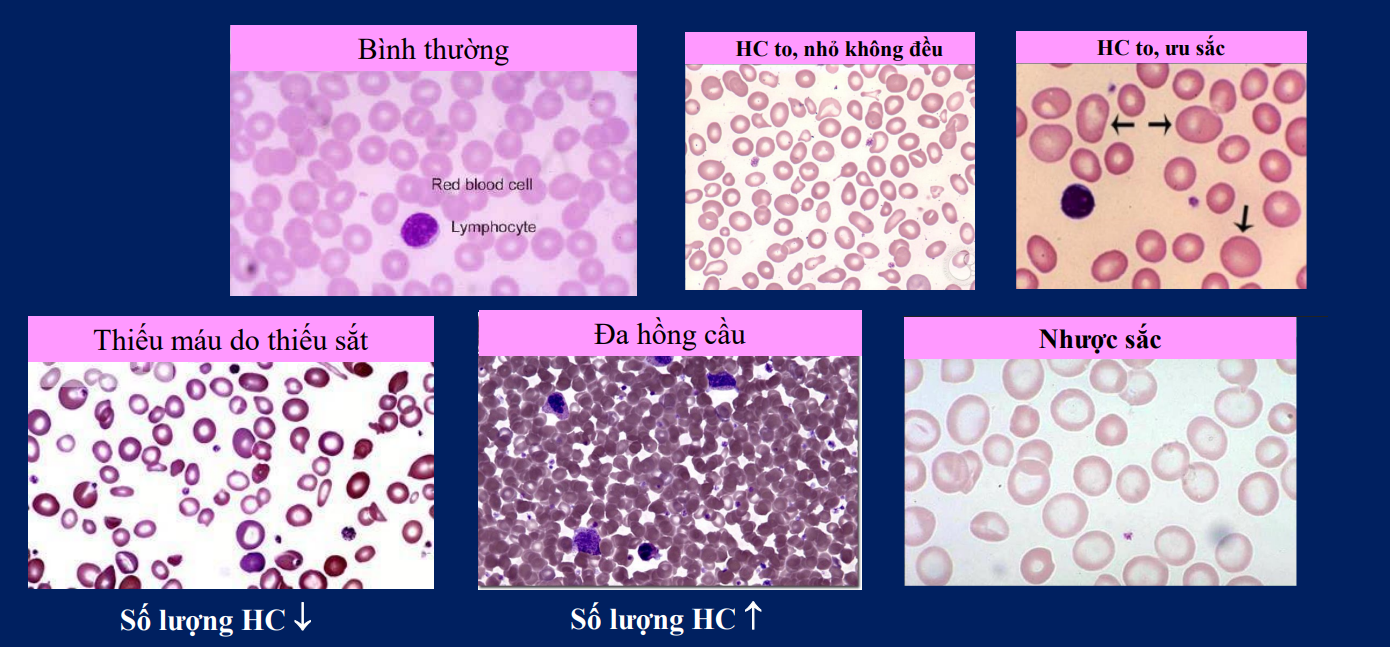
<p>Thiếu máu thiếu sắt:Thiếu Hb→nhược sắc, hồng cầu nhỏ, méo mó, vi trường thưa </p><p>Đa hồng cầu:Đa hồng cầu nguyên phát(tăng sinh tủy), thứ phát(thiếu máu oxy kéo dài→tăng ethyropoietin</p><p>Hồng cầu to nhỏ không đều:thiếu oxy hoặc các vấn đề di truyền, thiếu máu thiếu sắt→giải phóng cả hồng cầu lưới(hồng cầu non nên nhỏ), các hồng cầu méo mó các kiểu</p><p>Hồng cầu nhược sắc:thiếu máu thiếu sắc, bệnh tan máu…</p><p>Hồng cầu to, ưu sắc:hồng cầu khổng lồ(thiếu acid folic hoặc B12)</p>

Bài 1-Hệ máu
1/17
There's no tags or description
Looks like no tags are added yet.
Name | Mastery | Learn | Test | Matching | Spaced | Call with Kai |
|---|
No analytics yet
Send a link to your students to track their progress
18 Terms
Thành phần máu
Xét toàn cơ thể:máu(7-9%), còn lại là dịch khác
Xét trong máu:huyết tương(55%), lớp đệm(tiểu cầu và tb miễn dịch)-1%, Hồng cầu(44%)
Thành phần huyết tương:92%(nước), 7%(<1% của 7% là enzyme, hormone), 1%(chất khác-ion,khí..)
Lượng máu trong cơ thể là 75ml/kg

Xét dung tích hồng cầu(Hematocrit-HCT)
Bình thường HCT 36-45%→quá mức hồng cầu thì thường ta xem là bệnh mức nhẹ
Thiếu máu HCT <30%
Đa hồng cầu HCT >70%
Thiếu nước→giảm thể tích huyết tương→Tăng HCT lên 70%

Các bộ phận tham gia quá trình tạo 3 dòng Tb máu(hồng cầu, bạch cầu, tiểu cầu)
Trước sinh:túi noãn hoàng→gan→lách→tủy xương
Sau sinh:xét về tỉ trọng:xương sống, chậu→ức→sườn→hạch lympho→đùi→chày
Trong đó xương chày và đùi sẽ dừng tạo máu khi trưởng thành

Đặc điểm hồng cầu
Đĩa lõm 2 mặt
Đời sống 120 ngày
số lượng 3tr8-4tr5 hồng cầu/mm3(1 mm3=1 uL)
Cân bằng hồng cầu
Do erythropoietin(EPO) với xúc tác là nồng độ oxy máu
Nồng độ oxy thấp sẽ kích thích thận tiết Erythropoietin.Erythropoietin kích thích tủy đỏ tăng sản xuất hồng cầu

Các chức năng hồng cầu
Vận chuyển khí
Miễn dịch:Có thụ thể CR1→tạo phức kháng nguyên-Kháng thể-Bổ thể→đến gan lách
Cân bằng kiềm toan: Nhờ hệ đệm H2CO3(có enzyme carbonic anhydrase-CA)
Tạo áp suất keo
Chu trình của sắt trong cơ thể
Hấp thu và vận chuyển
Dự trữ
Tạo hồng cầu
Tái chế và tái lưu trữ
Đây là chu trình tự chia cho dễ mường tượng thôi

Quá trình hấp thu và vận chuyển sắt
Sắt được hấp thu ở đầu ruột non.
Chỉ 3-15% sắt được hấp thu còn lượng sắt còn lại sẽ thải qua phân
Sắt được vận chuyển trong máu nhờ gắn với transferri
Sắt có thể đến tủy xương để tham gia tạo máu hoặc dự trữ ở gan

Dự trữ sắt
Sắt dự trữ dưới 2 dạng:
-Ferritin-dạng hòa tan, dễ sử dụng
-Hemosiderin-dạng không hòa tan, được tạo ra khi Fe quá nhiều

Tái chế fe
Khi hồng cầu già(120 ngày tuổi) chúng sẽ được đại thực bào ở gan, lách, tủy xương phân giải.
Lượng Fe lúc này có thể được đi ngược vào máu và vận chuyển bởi Transferrin
Hoặc dự trữ ở đại thực bào dưới dạng ferritin và hemosiderin

Điều hòa lượng Fe trong máu
Fe muốn từ gan và đại thực bào đi vào máu cần phải qua các kênh ferro-portin.
Khi Fe máu thừa thì gan sẽ tiết hepcidin nhằm ức chế các kênh ferro-portin→ngăn sắt vào máu

Cơ chế tạo Deoxy-thymidylate
B9(folate) hấp thụ ở đoạn đầu ruột non.B12(cobalamin) gắn với IF của dạ dày rồi hấp thu ở hồi tràng
Cả 2 được dự trữ ở gan:B12(1mg), B9(7mg)
B9 tồn tại ở dạng N5-methyl-THF cần B12 khử methyl tạo THF
THF giúp chuyển Deoxy-U thành Deoxy-T→tạo hồng cầu ở tủy xương.
Các bệnh hồng cầu
Thiếu máu thiếu sắt:Thiếu Hb→nhược sắc, hồng cầu nhỏ, méo mó, vi trường thưa
Đa hồng cầu:Đa hồng cầu nguyên phát(tăng sinh tủy), thứ phát(thiếu máu oxy kéo dài→tăng ethyropoietin
Hồng cầu to nhỏ không đều:thiếu oxy hoặc các vấn đề di truyền, thiếu máu thiếu sắt→giải phóng cả hồng cầu lưới(hồng cầu non nên nhỏ), các hồng cầu méo mó các kiểu
Hồng cầu nhược sắc:thiếu máu thiếu sắc, bệnh tan máu…
Hồng cầu to, ưu sắc:hồng cầu khổng lồ(thiếu acid folic hoặc B12)
bạch cầu
Chi tiết bên phần mô học

Quá trình cầm máu máu
Cầm máu ban đầu:
Co mạch
Hình thành nút chận tiểu cầu
Cầm máu duy trì
Quá trình cầm máu ban đầu-Sự co mạch
Co mạch thần kinh:nhờ cung phản xạ tủy sống
Co mạch tại chỗ:tổn thương lên lớp cơ trơn làm thay đổi điện thế màng gây co cơ trơn
Co mạch nhờ các yếu tố thromboxane A2, secretonin, epinephrine(hệ giao cảm)
Cầm máu ban đầu-Hình thành nút chận tiểu cầu
-Lớp Tb nội mô tổn thương tiết vWF(von willebrand). vWF sẽ gắn glycoprotein(Ib) của tiểu cầu lên collagen tại vị trí tổn thương
-Tiểu cầu được hoạt hóa tiết ADP và thromboxane A2 để thu hút tiểu cầu khác tới
-Tiểu cầu khác hoạt hóa và gắn vào lớp tiểu cầu có sẵn nhờ glycoprotein IIb/IIIa
Cầm máu duy trì
-Hình thành prothrombinase
-Prothrombinase kích thích cắt prothrombin thành thrombin
-Thrombin kích thích fibrinogen thành fibrin và hoạt hóa yếu tố XIII(yếu tố ổn định fibrin)→tạo lưới fibrin
→giam giữ hồng cầu và bạch cầu